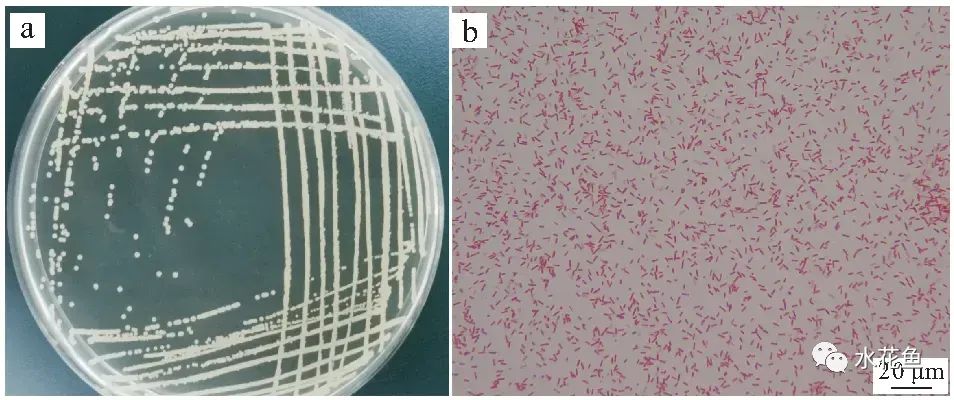
蛙歪头病：黑斑蛙歪头病病原米尔伊丽莎白菌分离、鉴定及特性分析

深知养殖从业不易,共谋水产行业繁荣。不误导不夸大不炒作不标题*党**。用养殖人的语境,让你在短时间内享用一份真材实料的精品!

黑斑蛙属两栖纲无尾目蛙科侧褶蛙属,又称黑斑侧褶蛙、青蛙,在我国广泛分布于除海南、云南、*藏西**、青海和台湾以外的各地区。黑斑蛙肉具有低脂肪、低胆固醇、高蛋白的优点,有较高的食用和药用价值,是我国近年来养殖蛙类中的主要品种之一。其养殖具有投入少、产出高、周期短、效益高等特点,近年来我国黑斑蛙养殖业发展十分迅猛。然而,随着黑斑蛙人工养殖规模的扩大,养殖环境出现恶化,加之不成熟的养殖技术,黑斑蛙的病害也逐年增多,给养殖户造成巨大经济损失。目前,已有致病性洛菲不动杆菌、嗜水气单胞菌、气单胞菌、肺炎克雷伯菌、米尔伊丽莎白菌、脑膜炎脓毒黄杆菌和脑膜败血伊丽莎白菌等感染黑斑蛙后导致其严重死亡的报道。

蛙歪头病,因蛙发病时颈部歪斜而得名,该病传染性强,死亡率高,目前尚无稳定有效的治疗方法,是蛙养殖过程中常见的疾病之一。2019年7月,湖北石首市大垸农场养殖黑斑蛙大面积死亡,病蛙出现典型的头部变歪、单侧或者双侧眼球浑浊发白和腹水症状,发病温度为25~28 ℃,发病率达80%,死亡率高达90%。对病蛙脑、肝、脾和肾脏进行病原菌分离,并通过病原菌的形态特征、生理生化特性、16S rRNA基因测序与系统发育对分离菌株进行鉴定,确定该病原菌的种属地位;然后通过人工感染试验和组织病理学分析确定该病原菌的致病性;最后通过药物敏感试验分析该病原菌的药物敏感性,以期为该病的临床防治用药提供科学指导和理论支撑。

(蛙歪头病)
1 材料与方法
1.1 材料
1.1.1 供试蛙
患病黑斑蛙取自湖北省石首大垸农场,采集患有歪头、单侧或者双侧眼球浑浊发白和腹水症状的黑斑蛙,共20只,平均体重为(48.0±1.0)g;健康黑斑蛙购自荆州市枣林铺黑斑蛙养殖基地,平均体重为(50.0±1.0)g,共140只,暂养于长江大学动科学院用于后续攻毒试验。
1.1.2 主要试剂
LB固体和液体培养基购自青岛海博有限公司,革兰氏染色液和苏木精伊红染色液购自北京索莱宝科技有限公司,API 20E试剂盒购自法国梅里埃生化公司,甲醛、二甲苯、无水乙醇和固体石蜡等购自国药集团化学试剂有限公司,药敏纸片购自杭州天和微生物试剂有限公司,Taq酶、dNTPs、细菌基因组提取试剂盒均购自大连宝生物工程有限公司,PCR扩增引物合成和扩增产物的测序均由武汉擎科创新生物科技有限公司完成。
1.1.3 主要仪器
光学显微镜购自奥林巴斯,PCR仪器购自SensoQuest,生物组织石蜡包埋机购自湖北安立信医疗实业有限公司,石蜡切片机购自德国徕卡。
1.2 病原菌分离纯化
无菌条件下从病蛙脑、肝、脾和肾等部位,用无菌接种环取样后划线接种于LB固体培养基,28 ℃培养24h,次日挑取平板上优势菌落,LB固体培养基纯化培养24h,取单菌落培养后4 ℃保存备用。从脑、肝、脾和肾四种组织中均分离到菌落形态相同的优势菌,选取脑组织中分离菌株为研究对象,暂命名为BSH3。
1.3 病原菌鉴定
1.3.1 形态学分析
将BSH3菌株划线接种于LB固体培养基上,置于28 ℃恒温培养箱中培养24 h,观察细菌菌落形态特征与颜色,测量菌落直径大小。挑选单菌落用革兰氏染色液进行革兰氏染色后,显微镜观察细菌染色特征。
1.3.2 生理生化特性分析
菌株BSH3的生理生化指标使用API 20E试剂盒进行检测,操作方法详见该试剂盒说明书,通过APIweb鉴定软件判读试验结果,并参照伯杰氏细菌鉴定手册中细菌生理生化指标进行确认。
1.3.3 分子生物学鉴定
将菌株从LB培养基上用蒸馏水洗脱下来,8000离心10min收集菌体。按细菌DNA提取试剂盒说明书抽提细菌基因组DNA,提取的总DNA即作为PCR扩增模板。用细菌通用性引物27F:5′-AGAGTTTGATCCTGGCTCAG-3′和1492R:5′-TACGGCTACCTTGTTACGACTT-3′进行16S rRNA基因PCR扩增。PCR扩增产物送至武汉擎科生物科技有限公司测序,通过GenBank中的BLAST程序进行序列同源性分析。*载下**GenBank中相关细菌16S rRNA 基因序列,通过Clustal X软件进行多重比对,用MEGA 6.0 软件中邻接法(neighbor joining,NJ)构建分子系统发育树。
1.4 组织病理学观察
取自然发病黑斑蛙的脑、肝、脾和肾组织(0.5cm×0.5cm×0.2cm),置于4%多聚甲醛固定液中固定48h后,进行常规石蜡切片和HE染色,Olympus显微镜下观察组织病理变化。
1.5 人工感染试验
健康黑斑蛙试验前在50cm×40cm×30cm的塑料筐中暂养2周,每框20只,共7框。框中加入曝气水使其淹过黑斑蛙背部,并放入一块泡沫板。暂养和试验期间水温保持在25~28 ℃,定期换水。暂养前进行抽样检测,确定试验用蛙不携带病原菌。
将分离纯化的菌株BSH3接种于LB液体培养基28 ℃振荡培养24h后,8000离心10min沉淀菌体,去上清后用无菌PBS稀释成浓度为1.0×10、1.0×10、1.0×10、1.0×10、1.0×10、1.0×10CFU/mL的菌液。将黑斑蛙随机分为6个感染组和1个阴性对照组,每组20只。采用大腿注射法进行人工感染,试验组每只注射0.2mL不同浓度菌悬液,对照组注射等体积的PBS。连续观察8d,每日早上9点和下午5点记录试验蛙的临床症状及死亡情况,并将刚死亡蛙的脑组织再次进行细菌分离与鉴定。采用寇氏法计算菌株BSH3的半致死浓度(LC)。
1.6 药物敏感试验
采用纸片琼脂扩散法检测菌株BSH3药物敏感性。首先将BSH3菌株接种于LB液体培养基,28 ℃振荡培养24 h后,8000离心10min沉淀菌体,用无菌PBS稀释菌体至0.5个麦氏浓度,取20μL菌悬液均匀涂布于LB固体平板上,待菌液被吸收后,向培养基贴不同抗生素药敏纸片,置于28 ℃恒温培养箱中倒置培养24h,测量抑菌圈直径,并参照产品说明书判断标准来判定结果。按相同方法每种药敏纸片重复3次。
2 结果
2.1 患病黑斑蛙临床症状
患病蛙的头部出现向一侧严重倾斜的症状(图1a),有些病蛙不仅具有歪头症状同时也出现了单侧或者双侧眼球浑浊发白的症状(图1b、c),另外部分病蛙出现腹部膨胀的症状(图1d),解剖发现蛙腹内有大量浅黄色腹水,肝脏充血肿大呈黄红相间的花斑肝(图e),病蛙肠道内无食物,充满透明状液体(图f)。

图1 患病黑斑蛙病变特征
2.2 细菌形态特征
BSH3菌株在LB平板上28 ℃培养24h后,可形成灰白色、圆形至椭圆形不等、中央微凸起、表面光滑、边缘整齐,直径在1~2mm的小菌落(图2a)。革兰氏染色为革兰氏阴性短杆菌,长1.0~2.0μm,宽0.5~0.8μm(图2b)。
图2 BSH3株形态学观察
2.3 16S rRNA基因序列分析
通过PCR扩增和克隆测序获得BSH3菌株的16S rRNA基因片段长度约为1500bp。将菌株基因序列在NCBI上进行BLAST在线对比,结果显示,菌株BSH3与米尔伊丽莎白菌16S rRNA基因序列(登录号:KY930330.1)的同源性达99.93%。*载下**GenBank中相关细菌16S rRNA基因序列,通过Clustal X软件进行多重比对,用MEGA6.0软件中邻接法(neighbor joining,NJ)构建分子系统发育树(图3)。结果显示,菌株BSH3与米尔伊丽莎白菌处于一个进化分支上。

图3 基于16S rRNA基因构建的菌株BSH3系统发育树
2.4 细菌生化鉴定
生理生化结果显示菌株BSH3能够利用脲素、Kohn明胶、山梨醇、麦芽糖、乳糖、葡萄糖和甘露醇,不能利用邻硝基苯-半乳糖苷、赖氨酸、鸟氨酸、柠檬酸钠、硫代硫酸钠、色氨酸、*酮丙**酸盐、肌醇、鼠李糖、蔗糖、蜜二糖、苦杏仁苷、阿拉伯糖和木糖(表1)。

表1 病原菌BSH3的生理生化特性
2.5 组织病理学
患病黑斑蛙肝脏组织出现大量褐色色素沉积,发生空泡变性和纤维素样变性(图4a);肾小管和肾小囊出现玻璃样变形,有大量炎性细胞浸润和出血现象(图4b);脾脏组织中发生空泡变性和玻璃样变形,并伴有炎性细胞浸润(图4c);脑基质水肿,胶质细胞增多,神经元细胞、胶质细胞周围空隙变大,基质中存在空泡,伴有出血现象(图4d)。

图4 患病黑斑蛙组织病理学观察
2.6 人工回归感染试验
菌株BSH3人工感染黑斑蛙后,蛙体出现不摄食,歪头、白内障、失去定向运动能力等神经性损伤症状。菌株浓度为1.0×10、1.0×10、1.0×10、1.0×10、1.0×10CFU/mL时,黑斑蛙的累计死亡率分别为100%、95%、85%、65%和25%。而注射浓度为1.0×10CFU/mL或PBS时,黑斑蛙在试验期间没有出现死亡。对病死蛙脑、肝、脾和肾等组织进一步进行细菌分离鉴定,经鉴定为米尔伊丽莎白菌,与自然患病蛙细菌分离鉴定结果一致,表明米尔伊丽莎白菌是造成此次黑斑蛙歪头病的病原菌。采用寇氏法计算该菌株对黑斑蛙的半数致死量(LC)为6.3×10CFU/mL(表2)。

表2 不同浓度分离菌株BSH3感染黑斑蛙死亡结果
2.7 药敏试验
菌株BSH3对23种抗菌药物的药敏试验结果见表3,结果表明分离菌株对米诺环素、氟苯尼考、利福平和万古霉素敏感,对氧哌嗪青霉素、羧苄西林、多西环素、复方新诺明、恩洛沙星和萘啶酸中度敏感,对青霉素G、阿莫西林、氨苄青霉素、头孢氨苄、头孢他啶、头孢克洛、氨曲南、吡哌酸、庆大霉素、链霉素、卡那霉素、丁胺卡那、新霉素和多粘菌素B等多种药物耐药。

表3 菌株BSH3的药敏试验结果
3 讨论
3.1 歪头病病原及主要症状
歪头病是蛙类养殖过程中危害较大的疾病之一,通常还伴有白内障、腹水等并发症。不同患病个体表现出来的具体症状也有所不同,急性患病个体只表现出歪头症状,不表现白内障和腹水等症状;而在慢性患病个体中,歪头、白内障和腹水三种症状均可表现出来。导致病蛙出现急性和慢性感染的主要原因是细菌感染的部位不同,在急性歪头病蛙中只能从脑部分离到大量病菌,而在出现三种症状的慢性病蛙可以同时从眼、脑、肝、肾和腹水等部位分离到相同致病菌。本实验中,患病黑斑蛙临床特征主要表现为食欲减退,歪头,白内障和腹水等,这与Hu等报道的米尔伊丽莎白菌引起黑斑蛙歪头病的结果一致。其中,歪头和白内障具有代表性,可以作为临床上诊断该病的重要依据。
在鱼类和蛙养殖过程中均有白内障病的报道,但引起两者出现白内障的病原存在差异。引起鱼类眼球表面出现白内障的病原为寄生虫,如复口吸虫的尾蚴和囊蚴等可以引起鱼类白内障病。目前,已报道的棘胸蛙、青蛙、黑斑蛙、棘腹蛙、牛蛙、虎纹蛙、刺蛙等蛙类白内障(歪头)则均是由细菌引起。其中,主要是由伊丽莎白菌属(spp.)的脑膜败血伊丽莎白菌()所引起。
3.2 米尔伊丽莎白菌的致病性
米尔伊丽莎白菌为革兰氏阴性杆菌,隶属于黄杆菌科伊丽莎白菌属,广泛分布于淡水和土壤中。2003年该菌首次从和平空间站冷凝水中被分离到。此后,研究发现该菌可引起人类腹膜炎、肺炎、脑膜炎、蜂窝组织炎、败血症和眼部感染等症状。米尔伊丽莎白菌可感染多种无尾类动物,在黑斑蛙、刺蛙、豹蛙、树蛙和微蹼铃蟾等中均有发现,出现歪头、白内障和腹水等症状,并导致大量患病死亡。本研究中,人工回归感染试验表明米尔伊丽莎白菌BSH3的半数致死量为6.3 × 10CFU/mL,具有较强的致病性。然而,Huang等研究中,米尔伊丽莎白菌的致死率相对偏低,说明不同分离株的致病力存在差异。
实验对患病蛙脑、肝、脾和肾脏进行组织病理观察,发现米尔伊丽莎白菌感染黑斑蛙后可引起蛙这些组织损伤。尤其是蛙脑基质轻度水肿,胶质细胞明显增多,胶质细胞、神经元细胞周围空隙增大,基质中有空泡。这与伊丽莎白菌引起蛙类脑部病理观察结果是一致的。当蛙体质下降并受到病原侵害时,病原躲过了蛙体的免疫防御,在蛙体内定植并不断繁殖,沿着某种路径侵入大脑,造成大脑的各类炎症和机能障碍,出现了歪头、旋游、定向能力失调的症状。另外,病蛙肝、脾和肾脏出现变性、坏死和炎症细胞浸润等病变。由此可见,患病的黑斑蛙病灶并不仅仅局限于脑部,其他内脏器官也不同程度受到感染且更加严重,多器官坏死、衰竭最终加速了病蛙的死亡。本实验中从病蛙的脑、肝、脾、肾组织中均分离到致病菌株,暗示病原菌是导致蛙组织损伤的原因。胡瑞雪从患病蛙脑组织分离到一株米尔伊丽莎白菌FL160902,该菌可引起蛙肝、脾、肾、脑不同程度的损伤,其中以脑部病变最为明显。此外,秦振阳从湖南岳阳发生歪头病的黑斑蛙脑部、眼球、肝脏、卵巢等多处组织器官分离到一株米尔伊丽莎白菌分离株HNW1681,可以引起蛙心脏、肝脏、脑、眼等不同程度的病理变化。这些研究表明米尔伊丽莎白菌对黑斑蛙的感染是呈全身性的,并且引起蛙全身性组织损伤。
3.3 黑斑蛙歪头病的防控建议
本实验药敏试验结果显示,米尔伊丽莎白菌BSH3仅对米诺环素、氟苯尼考、利福平和万古霉素四种药物敏感。然而,利福平和万古霉素这两种药在水产上是禁用药,所以在黑斑蛙患歪头病时应禁止使用。米诺环素和氟苯尼考是农业部批准使用的水产药物,生产中可用盐酸米诺环素粉剂100g拌料1000kg,连用5~7d或每kg体重拌饲投喂15~20mg氟苯尼考粉,每天一次,连用3~5d。但过度使用米诺环素易使水体污染和对水生生物产生毒性作用,因此生产中尽量不使用米诺环素治疗黑斑蛙歪头病。吴兴镇发现五味子、柯子、半枝莲、五倍子,乌梅等植物*药性**物在控制伊丽莎白菌感染时起到了良好的效果,加强植物*药性**物的研发与使用可能是将来有效防治伊丽莎白菌病的重要途径。此外,米尔伊丽莎白菌能够侵害蛙的神经器官,比如大脑,可以在细胞间基质外生存,甚至少数细菌可以进入细胞质。在治疗该病时,可以考虑使用一些更容易穿透血脑屏障的脂溶*药性**物,如磺胺类药物。周永灿等研究发现脑膜炎败血伊丽莎白菌全菌疫苗能够在一定程度上预防虎纹蛙白内障疾病的发生,这为利用免疫学方法防控伊丽莎白菌病提供了理论依据与数据支持。
在水产养殖过程中需要采用“以防为主,防治结合”的综合防治方法。抗生素的长期使用会导致细菌耐药性的产生和水体环境的污染。应用疫苗开展疾病的免疫防治不仅可以提高动物自身的免疫水平、增强机体的抗病能力,而且还符合绿色环保的要求,将是水生动物疾病防治的主流发展方向。
4 结论
本研究通过形态学、生理生化特性分析与分子生物学相结合的方法,从患歪头病黑斑蛙体内分离到致病菌株米尔伊丽莎白菌,命名为BSH3。病理组织观察米尔伊丽莎白菌可以引起黑斑蛙全身性组织病理损伤。通过药物敏感试验,初步筛选出氟苯尼考可用于黑斑蛙歪头病的防控。
(来源:淡水渔业2022年3期)
(作者:李川北,阮陈松杰,吴明波,徐洪森,苏应兵。长江大学动物科学学院,武汉轻工大学动物科学与营养工程学院)

水产实践人士,共谋渔业繁荣!敬请关注头条号@渔人刘文俊,更多精彩内容请登录西南渔业网和养鱼第一线公众号,本文原创如需转载请注明出处,更多精彩内容请登录西南渔业网和"养鱼第一线"公众号,如有不同见解或者内容补充请私信或留言或评论分享!#水产养殖##头条创作挑战赛##鱼病##渔人刘文俊##鱼病防治#